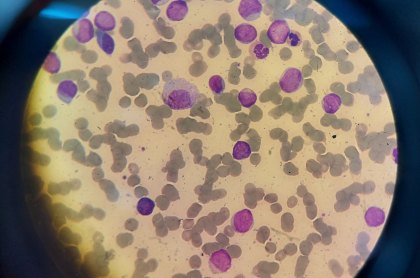

نشمین
نشمین (نَشْم + ین) یعنی گلی که برای اولین بار جوانه میزند (+). نزدیک بهار است. زمانی مناسب برای این نام. حرفهایی که در ادامه مینویسم، کمی در مورد نشمین هستند و بیشتر به بهانهی نشمین. نشمین از آخرین بیمارهای من به عنوان دستیار سال یک بود. البته که اسم او نشمین نبود ولی به […]